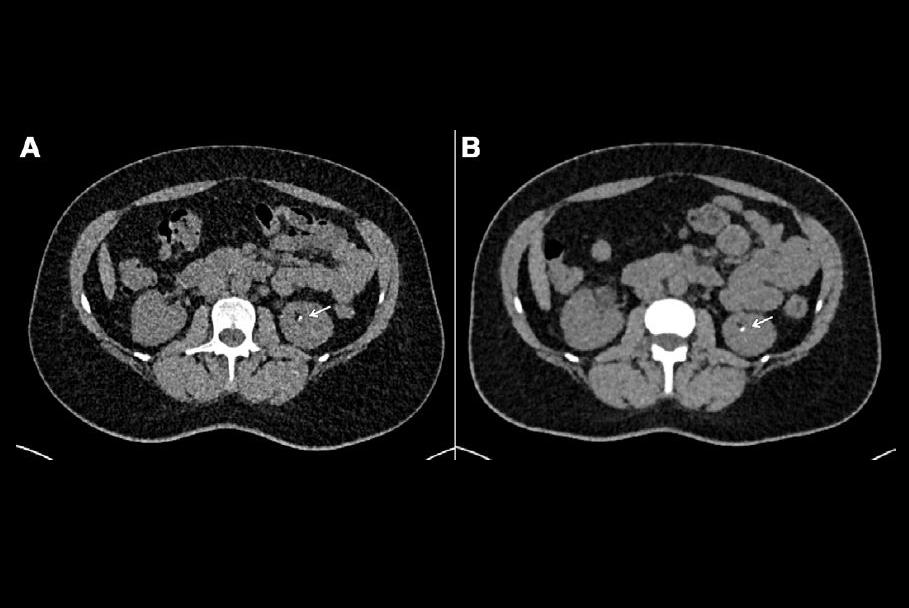
2024 07 30 Radiology Huflage Figure2 Thumbnail

VIENNA - ECR 2023 kicked off with high enthusiasm for photon-counting CT (PCCT) as researchers shared data about the technology's benefits.
Study findings delivered on March 1 highlighted results for indications ranging from assessments of coronary artery and lung disease to the evaluation of spine surgery outcomes, focusing on how PCCT improves image quality and reduces radiation dose.
Gauging heart health
Ultrahigh resolution PCCT coronary CT angiography (CCTA) produces high image quality in 80% of coronary segments at high heart rates -- with moderate radiation dose and limited artifacts, found a team led by Dr. Simran Sharma of Erasmus University Medical Center in Rotterdam, the Netherlands.
Sharma and colleagues performed a study that included 32 patients who underwent an ultrahigh CCTA with PCCT. The group measured contrast-to-noise and signal-to-noise ratios in ascending aorta and subcutaneous fatty tissue, and an experienced radiologist scored image quality on a five-point scale; the reader also noted the presence of motion or stack artifacts. Mean radiation dose (CTDIvol) was 19.1 mGy, mean dose length product (DLP) was 257, mean signal-to-noise ratio was 9.5, and contrast-to-noise ratio was 11.8. Motion artifacts were found in 34 segments, stack artifacts in 31, and other artifacts (metal or stent) in five segments.
Of a total of 576 coronary segments possible for evaluation, 443 were viable; of these, the group found that 80% of the segments' image quality on CCTA using PCCT was ranked as very good (22%) or excellent (58%), while only 3% were ranked as poor.
"Ultrahigh-resolution dual-source PCCT CCTA provides excellent or very good image quality in 80% of coronary segments at high heart rates at moderate radiation dose with only limited stack artifacts," Sharma concluded.
Illuminating interstitial lung disease
Ultrahigh-resolution PCCT imaging offers more specific clinical information than high-resolution CT exams for the evaluation of interstitial lung disease caused by rheumatoid arthritis -- although it does impart higher doses of radiation, according to a presentation delivered by Dr. Nikolett Marton of Semmelweis University in Budapest, Hungary.
The team compared the performance of high-resolution CT to PCCT via a study that included 59 rheumatoid arthritis patients without current diagnosis of interstitial lung disease. Each patient underwent two CT exams, one at 0.4 mm slice thickness (high-resolution) and another at 0.2 mm slice thickness (ultrahigh resolution). The exams were assessed for characteristics such as ground-glass opacity, bronchiectasis, reticulation, and honeycombing, with each of these graded using a five-point scoring system; the group calculated a total interstitial lung disease score by the sum of the scores from both lobes.
High-resolution conventional CT imaging had lower total dose length product (p < 0.001) compared with the ultrahigh resolution PCCT scans, but PCCT offered more clinical data in the form of higher interstitial lung disease scores, at six versus four (indicating elevated reticulation, bronchiectasis, and honeycombing).
"Ultrahigh-resolution [PCCT] protocol provides more detailed information regarding the extent of interstitial involvement in patients with rheumatoid arthritis compared to high resolution [PCCT] measurement," Marton noted.
Shining light on the spine
In a third talk, presenter Dr. Jakob Weiss of the University Medical Center Freiburg in Germany shared results from a study that explored the benefits of using artificial intelligence (AI) and PCCT to image the spine post surgery.
Weiss and colleagues conducted a study that included 32 patients referred for PCCT of the spine after surgical placement of metal implants. Four radiologists compared the image quality of the PCCT exams to conventional CT exams, and Weiss's team evaluated radiation dose used for each type of exam.
The group found that the four readers ranked image sharpness on PCCT imaging as significantly higher than on conventional CT (p = 0.009) and noise as significantly lower (p < 0.001). Radiation dose was also significantly lower, at 8.83 mGy compared to 15.7 mGy.
"[PCCT] of the spine with high keV reconstructions provides significantly sharper images and higher diagnostic confidence in patients with metallic implants while radiation dose was significantly reduced," Weiss concluded.